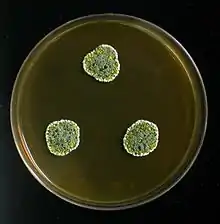

List of Penicillium species
This is a list of Penicillium species. The genus has over 300 species.[1]
Species
A
- Penicillium abidjanum[2]
- Penicillium adametzii[2]
- Penicillium adametzioides[2]
- Penicillium aeris[3]
- Penicillium aethiopicum[2]
- Penicillium albicans[2]
- Penicillium albidum [2]
- Penicillium albocoremium
- Penicillium alexiae[4]
- Penicillium alfredii[5]
- Penicillium alicantinum[4]
- Penicillium allahabadense[6]
- Penicillium allii
- Penicillium allii-sativi[4]
- Penicillium alogum[3]
- Penicillium alutaceum[2]
- Penicillium anatolicum[2]
- Penicillium amagasakiense[4]
- Penicillium amaliae[4]
- Penicillium amphipolaria[3]
- Penicillium anatolicum[4]
- Penicillium angulare[4]
- Penicillium angustiporcatum[2]
- Penicillium antarcticum[4]
- Penicillium annulatum[3]
- Penicillium aotearoae[3]
- Penicillium araracuarense[4]
- Penicillium ardesiacum[4]
- Penicillium arenicola[4]
- Penicillium aragonense[2]
- Penicillium arianeae[4]
- Penicillium ardesiacum[2]
- Penicillium arenicola[2]
- Penicillium argentinense
- Penicillium armarii[5]
- Penicillium astrolabium[4]
- Penicillium asturianum[2]
- Penicillium atramentosum[2]
- Penicillium athertonense[5]
- Penicillium atrolazulinum[3]
- Penicillium attenuatum[3]
- Penicillium atrosanguineum[2]
- Penicillium atrovenetum[2]
- Penicillium austricola[3]
- Penicillium aurantiacobrunneum[5]
- Penicillium aurantiogriseum[2]
- Penicillium aureocephalum[2]
- Penicillium austroafricanum[5]
- Penicillium austrosinicum[3]
B
- Penicillium bilaiae[2]
- Penicillium bissettii[7]
- Penicillium boreae[2]
- Penicillium bovifimosum[4]
- Penicillium brasilianum[2]
- Penicillium brasiliense
- Penicillium brefeldianum[4]
- Penicillium brevicompactum[2]
- Penicillium brevissimum[2]
- Penicillium brevistipitatum[4]
- Penicillium brocae[2]
- Penicillium brunneoconidiatum[5]
- Penicillium brunneum[2]
- Penicillium buchwaldii[4]
- Penicillium burgense[4]
- Penicillium bussumense[5]
C
- Penicillium caerulescens[2]
- Penicillium cainii[4]
- Penicillium cairnsense[4]
- Penicillium calidicanium[2]
- Penicillium camemberti[2]
- Penicillium camponotum[8]
- Penicillium canariense[2]
- Penicillium canescens[2]
- Penicillium canis[5]
- Penicillium cantabricum[8]
- Penicillium caperatum[4]
- Penicillium capsulatum[2]
- Penicillium carneum[2]
- Penicillium cartierense[5]
- Penicillium caseifulvum[4]
- Penicillium catalonicum[8]
- Penicillium cataractarum[8]
- Penicillium catenatum[2]
- Penicillium cavernicola[4]
- Penicillium cecidicola[4]
- Penicillium cellarum[8]
- Penicillium chalabudae[8]
- Penicillium chalybeum[2]
- Penicillium charlesii[4]
- Penicillium chermesinum [2]
- Penicillium choerospondiatis[8]
- Penicillium christenseniae[4]
- Penicillium chroogomphum[8]
- Penicillium chrysogenum[2]
- Penicillium cinnamopurpureum[4]
- Penicillium citrinum[2]
- Penicillium citrioviride[4]
- Penicillium clavigerum[4]
- Penicillium clavistipitatum[5]
- Penicillium claviforme[2]
- Penicillium cluniae[5]
- Penicillium coalescens[2]
- Penicillium coccotrypicola[5]
- Penicillium coeruleum[2]
- Penicillium coffeae[4]
- Penicillium columnare
- Penicillium commune[2]
- Penicillium compactum[8]
- Penicillium concentricum[4]
- Penicillium confertum[4]
- Penicillium contaminatum[5]
- Penicillium coprobium[2]
- Penicillium coprophilum[2]
- Penicillium copticola[4]
- Penicillium coralligerum[4]
- Penicillium corylophilum[2]
- Penicillium corynephorum[2]
- Penicillium corvianum[8]
- Penicillium cosmopolitanum[4]
- Penicillium cremeogriseum[4]
- Penicillium crustosum[2]
- Penicillium cryptum[4]
- Penicillium crystallinum[5]
- Penicillium costaricense[8]
- Penicillium cravenianum[8]
- Penicillium curticaule[8]
- Penicillium cvjetkovicii[8]
- Penicillium cyaneum[2]
D
- Penicillium daejeonium[5]
- Penicillium daleae[4]
- Penicillium decaturense[4]
- Penicillium decumbens[2]
- Penicillium dendriticum[2]
- Penicillium desertorum[4]
- Penicillium diabolicalicense[9]
- Penicillium dierckxii[2]
- Penicillium digitatum[2]
- Penicillium dimorphosporum[2]
- Penicillium dipodomyicola[4]
- Penicillium dipodomyis[4]
- Penicillium discolor[2]
- Penicillium diversum[2]
- Penicillium dodgei[2]
- Penicillium donkii[2]
- Penicillium dravuni[2]
- Penicillium duclauxii[2]
- Penicillium dunedinense[5]
E
F
- Penicillium fasciculatum[2]
- Penicillium fennelliae[2]
- Penicillium fimorum[11]
- Penicillium flavescens[4]
- Penicillium flavidostipitatum[2]
- Penicillium flavigenum[2]
- Penicillium flavisclerotiatum[5]
- Penicillium fluviserpens[11]
- Penicillium formosanum[2]
- Penicillium fractum[2]
- Penicillium freii[2]
- Penicillium funiculosum[2]
- Penicillium fundyense[11]
- Penicillium fusisporum[5]
G
- Penicillium georgiense[4]
- Penicillium giganteum[4]
- Penicillium gladioli[2]
- Penicillium glabrum[4]
- Penicillium glandicola[4]
- Penicillium glaucoalbidum[4]
- Penicillium glaucum[2]
- Penicillium glycyrrhizacola[5]
- Penicillium goetzii[4]
- Penicillium gossypii [2]
- Penicillium gorlenkoanum[4]
- Penicillium gracilentum[2]
- Penicillium grevilleicola[5]
- Penicillium griseofulvum[2]
- Penicillium griseolum[2]
- Penicillium griseopurpureum[5]
- Penicillium griseum[4]
- Penicillium guanacastense[4]
H
- Penicillium halotolerans[4]
- Penicillium hemitrachum[12]
- Penicillium hennebertii[5]
- Penicillium herquei[2]
- Penicillium heteringtonii[4]
- Penicillium heteromorphum [2]
- Penicillium hetheringtonii[4]
- Penicillium hirayamae[4]
- Penicillium hirsutum[4]
- Penicillium hispanicum[2]
- Penicillium humicola[13]
- Penicillium hoeksii[5]
- Penicillium hordei[2]
- Penicillium humicoloides[4]
- Penicillium humuli[2]
- Penicillium hypomycetis[2]
I
- Penicillium ianthinellum[4]
- Penicillium idahoense[4]
- Penicillium implicatum[2]
- Penicillium improvisum[14]
- Penicillium incoloratum[2]
- Penicillium indonesiae[4]
- Penicillium inflatum[2]
- Penicillium intermedium[2]
- Penicillium infra-aurantiacum[5]
- Penicillium infrabuccalum[14]
- Penicillium infrapurpureum[5]
- Penicillium imranianum [15]
- Penicillium inusitatum[2]
- Penicillium isariiforme[2]
- Penicillium islandicum[2]
- Penicillium italicum[2]
J
K
L
- Penicillium lacus-sarmientei[2]
- Penicillium laeve[5]
- Penicillium lapatayae[2]
- Penicillium lapidosum[2]
- Penicillium lassenii[2]
- Penicillium lemhiflumine[18]
- Penicillium lehmanii[2]
- Penicillium lenticrescens[5]
- Penicillium levitum[4]
- Penicillium lignorum[2]
- Penicillium limosum[2]
- Penicillium lineatum[2]
- Penicillium loliense[2]
- Penicillium longicatenatum[5]
- Penicillium ludwigii[2]
M
- Penicillium macrosclerotiorum[4]
- Penicillium maclennaniae[2]
- Penicillium madriti[2]
- Penicillium magnielliptisporum[5]
- Penicillium malacaense[2]
- Penicillium malacosphaerulum[19]
- Penicillium mallochii[4]
- Penicillium malmesburiense[5]
- Penicillium mariae-crucis[2]
- Penicillium marinum[4]
- Penicillium marthae-christensenia[19]
- Penicillium maximae[4]
- Penicillium megasporum[2]
- Penicillium melanoconidium[2]
- Penicillium melinii[2]
- Penicillium menonorum[4]
- Penicillium meloforme[2]
- Penicillium meridianum[4]
- Penicillium mexicanum[5]
- Penicillium miczynskii[2]
- Penicillium momoii[19]
- Penicillium mimosinum[2]
- Penicillium minioluteum[2]
- Penicillium moldavicum[2]
- Penicillium molle[2]
- Penicillium mononematosum[4]
- Penicillium monsgalena[19]
- Penicillium monsserratidens[19]
- Penicillium montanense[2]
- Penicillium multicolor[2]
- Penicillium murcianum[2]
N
- Penicillium nalgiovense[2]
- Penicillium neocrassum[4]
- Penicillium neoechinulatum[2]
- Penicillium neomiczynskii[4]
- Penicillium nepalense[2]
- Penicillium nilense[2]
- Penicillium nodositatum[2]
- Penicillium nodulum[2]
- Penicillium nordicum[4]
- Penicillium nothofagi[4]
- Penicillium novae-zelandiae[2]
- Penicillium nucicola[20]
O
- Penicillium ochotense[21]
- Penicillium oblatum[2]
- Penicillium occitanis[4]
- Penicillium ochrochloron[2]
- Penicillium ochrosalmoneum[2]
- Penicillium olsonii[2]
- Penicillium onobense[2]
- Penicillium oregonense[21]
- Penicillium ootensis[2]
- Penicillium ornatum[2]
- Penicillium ortum[21]
- Penicillium osmophilum[2]
- Penicillium ovatum[5]
- Penicillium oxalicum [2]
P
- Penicillium pagulum[22]
- Penicillium pachmariensis[2]
- Penicillium palitans[2]
- Penicillium palmae[2]
- Penicillium panamense[2]
- Penicillium pancosmium[4]
- Penicillium paneum[2]
- Penicillium panissanguineum[22]
- Penicillium paradoxum[5]
- Penicillium parviverrucosum
- Penicillium parvofructum[22]
- Penicillium parvulum[4]
- Penicillium parvum[4]
- Penicillium pasqualense[4]
- Penicillium parmonense[2]
- Penicillium patens[2]
- Penicillium paxilli[2]
- Penicillium pedernalense[22]
- Penicillium penarojense[5]
- Penicillium persicinum[4]
- Penicillium philippinense[4]
- Penicillium phoeniceum[2]
- Penicillium piltunense[22]
- Penicillium piceum[2]
- Penicillium pimiteouiense[2]
- Penicillium pinophilum[2]
- Penicillium pinsaporum[2]
- Penicillium polonicum[2]
- Penicillium primulinum[2]
- Penicillium proteolyticum[2]
- Penicillium pseudostromaticum[2]
- Penicillium psychrosexualis[4]
- Penicillium pullum[2]
- Penicillium pulvis[5]
- Penicillium punicae[22]
- Penicillium punicae[4]
- Penicillium purpurescens[2]
- Penicillium purpureum[2]
- Penicillium purpurogenum[2]
R
- Penicillium raciborskii[4]
- Penicillium rademirici[2]
- Penicillium radicicola[4]
- Penicillium radicum[2]
- Penicillium raistrickii[2]
- Penicillium ramusculum[4]
- Penicillium ranomafanaense[5]
- Penicillium raphiae[4]
- Penicillium repensicola[23]
- Penicillium rasile[2]
- Penicillium resedanum[2]
- Penicillium resticulosum[2]
- Penicillium restingae[5]
- Penicillium restrictum[2]
- Penicillium ribium[4]
- Penicillium riverlandense[23]
- Penicillium robsamsonii[23]
- Penicillium rolfsii[2]
- Penicillium roqueforti[2]
- Penicillium roseopurpureum[2]
- Penicillium rubefaciens[2]
- Penicillium rubidurum[2]
- Penicillium rubrum[2]
- Penicillium rudallense[5]
- Penicillium rugulosum[2]
S
- Penicillium sabulosum[2]
- Penicillium sacculum[5]
- Penicillium sajarovii[2]
- Penicillium salamii[24]
- Penicillium salmoniflumin[25]
- Penicillium samsonianum[25]
- Penicillium sanguifluum[4]
- Penicillium sanshaense[4]
- Penicillium scabrosum[2]
- Penicillium sclerotigenum[2]
- Penicillium senticosum[2]
- Penicillium severskii[2]
- Penicillium shennonghianum[2]
- Penicillium siamense[2]
- Penicillium simile[4]
- Penicillium simplicissimum[2]
- Penicillium sinaicum[2]
- Penicillium singorense[5]
- Penicillium sizovae[4]
- Penicillium skrjabinii[4]
- Penicillium smithii[2]
- Penicillium solitum[2]
- Penicillium soppii[4]
- Penicillium spathulatum[4]
- Penicillium sphaerum[2]
- Penicillium spinulosum[2]
- Penicillium spirillum[2]
- Penicillium steckii
- Penicillium sterculiniicola[5]
- Penicillium striatisporum[4]
- Penicillium stolkiae[2]
- Penicillium subarcticum[2]
- Penicillium subericola[4]
- Penicillium sublateritium[2]
- Penicillium sublectaticum[5]
- Penicillium subrubescens[4]
- Penicillium subspinulosum[5]
- Penicillium subturcoseum[2]
- Penicillium sucrivorum[5]
- Penicillium sumatrense[4]
- Penicillium svalbardense[4]
- Penicillium sylvaticum[4]
T
- Penicillium tanzanicum[26]
- Penicillium tardochrysogenum[4]
- Penicillium tardum[4]
- Penicillium tarraconense[2]
- Penicillium terrenum[4]
- Penicillium terrigenum[4]
- Penicillium thiersii[4]
- Penicillium thomii[2]
- Penicillium thymicola[2]
- Penicillium tricolor[2]
- Penicillium tropicoides[4]
- Penicillium tropicum[4]
- Penicillium tsitsikammaense[4]
- Penicillium tubakianum[26]
- Penicillium tulipae[4]
- Penicillium turbatum[2]
- Penicillium turcosoconidiatum[4]
V
- Penicillium vagum[4]
- Penicillium vancouverense[4]
- Penicillium vanbeymae[2]
- Penicillium vanderhammenii[4]
- Penicillium vanluykii[4]
- Penicillium vanoranjei[27]
- Penicillium variratens[28]
- Penicillium variabile[2]
- Penicillium vasconiae[2]
- Penicillium velutinum[2]
- Penicillium venetum[4]
- Penicillium verhagenii[4]
- Penicillium verrucisporum[28]
- Penicillium verrucosum[2]
- Penicillium verruculosum[2]
- Penicillium vinaceum[2]
- Penicillium virgatum[2]
- Penicillium viridicatum
- Penicillium viticola[29]
W
- Penicillium waksmanii[2]
- Penicillium wellingtonense[4]
- Penicillium westlingii [2]
- Penicillium williamettense[30]
- Penicillium wisconsinense[30]
- Penicillium wollemiicola[30]
- Penicillium wotroi[4]
References
- Chang, JCS; Foarde, KK; Vanosdell, DW. (1995). "Growth evaluation of fungi (Penicillium and Aspergillus spp.) on ceiling tiles". Atmospheric Environment. 29 (17): 2331 37. doi:10.1016/1352-2310(95)00062-4.
- eol.org
- User, Super. "Penicillium species A". www.aspergilluspenicillium.org.
- UniProt
- ICPA A commission of the International Union of Microbiological Societies Archived 2015-01-10 at the Wayback Machine
- MycoBank
- User, Super. "Penicillium names B". www.aspergilluspenicillium.org.
- User, Super. "Penicillium names C". www.aspergilluspenicillium.org.
- User, Super. "Penicillium names D". www.aspergilluspenicillium.org.
- User, Super. "Penicillium names E". www.aspergilluspenicillium.org.
- User, Super. "Penicillium names F". www.aspergilluspenicillium.org.
- User, Super. "Penicillium names H". www.aspergilluspenicillium.org.
- Ismail, S.; Khattab, O. K.; Nour, S.; Abo-Elnasr, A.; El-Refai, M.; Hashem, A. (2014). "Improved mannanase production from Penicillium humicola and application for hydrolysis property". Egyptian Pharmaceutical Journal. 13 (2): 160. doi:10.4103/1687-4315.147102.
- User, Super. "Penicillium names I". www.aspergilluspenicillium.org.
- Park MS, Fong JJ, Oh SY, Houbraken J, Sohn JH, Hong SB, Lim YW (2015). "Penicillium jejuense sp. nov., isolated from the marine environments of Jeju Island, Korea". Mycologia. 107 (1): 209–16. doi:10.3852/14-180. PMID 25361832.
- You, Y. H.; Cho, H. S.; Song, J; Kim, D. H.; Houbraken, J; Hong, S. B. (2014). "Penicillium koreense sp. nov., Isolated from Various Soils in Korea". Journal of Microbiology and Biotechnology. 24 (12): 1606–8. doi:10.4014/jmb.1406.06074. PMID 25262684.
- User, Super. "Penicillium names L". www.aspergilluspenicillium.org.
- User, Super. "Penicillium names M". www.aspergilluspenicillium.org.
- User, Super. "Penicillium names N". www.aspergilluspenicillium.org.
- User, Super. "Penicillium names O". www.aspergilluspenicillium.org.
- User, Super. "Penicillium names P". www.aspergilluspenicillium.org.
- User, Super. "Penicillium names R". www.aspergilluspenicillium.org.
- Perrone, Giancarlo (2015). "Penicillium salamii, a new species occurring during seasoning of dry-cured meat". International Journal of Food Microbiology. 193: 91–98. doi:10.1016/j.ijfoodmicro.2014.10.023. PMID 25462928.
- User, Super. "Penicillium names S". www.aspergilluspenicillium.org.
- User, Super. "Penicillium names T". www.aspergilluspenicillium.org.
- MycoBank
- User, Super. "Penicillium names V". www.aspergilluspenicillium.org.
- Nonaka, K.; Masuma, R.; Iwatsuki, M.; Shiomi, K.; Otoguro, K.; Omura, S. (2011). "Penicillium viticola, a new species isolated from a grape in Japan". Mycoscience. 52 (5): 338. doi:10.1007/s10267-011-0114-7.
- User, Super. "Penicillium names W". www.aspergilluspenicillium.org.
Further reading
- Nicoletti R, Ciavatta ML, Buommino E, Tufano MA (2008). "Antitumor extrolites produced by Penicillium species" (PDF). Int. J. Biomed. Pharm. Sci. 2 (1): 1–23. Archived from the original (PDF) on 2014-12-26. Retrieved 2014-12-26.
- BOLDSYSTEMS
- Visagie, C. M.; Houbraken, J.; Frisvad, J. C.; Hong, S. -B.; Klaassen, C. H. W.; Perrone, G.; Seifert, K. A.; Varga, J.; Yaguchi, T.; Samson, R. A. (2014). "Identification and nomenclature of the genus Penicillium". Studies in Mycology. 78: 343–371. doi:10.1016/j.simyco.2014.09.001. PMC 4261876. PMID 25505353.
- ICPA A commission of the International Union of Microbiological Societies
- gni Global Names Index beta
- Samson RA, Seifert KA, Kuijpers AF, Houbraken JA, Frisvad JC (2004). "Phylogenetic analysis of Penicillium subgenus Penicillium using partial β-tubulin sequences" (PDF). Studies in Mycology. 49: 175–200. Archived from the original (PDF) on 2015-02-05. Retrieved 2015-02-05.
- Ramírez, Carlos (1982). Manual and atlas of the Penicillia. Elsevier. ISBN 0444803696.
- Samson, Robert A.; Pitt, J.I. (2000). Integration of Modern Taxonomic Methods For Penicillium and Aspergillus Classification. CRC Press. ISBN 9058231593.
This article is issued from Wikipedia. The text is licensed under Creative Commons - Attribution - Sharealike. Additional terms may apply for the media files.